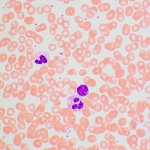
Биологичен микроскоп MAGUS Bio 270T

Биологичен микроскоп MAGUS Bio 270T

Информация
Изследователски клас микроскоп. Конструиран за наблюдение на прозрачни и полупрозрачни биологични проби, като например натривки и напречни сечения в преминаваща светлина по метода на светлото поле. Монтирането на допълнителни принадлежности ще осигури възможност за използване на методите на тъмното поле, фазовия контраст, флуоресценцията и поляризацията.
Кодираната револверна глава поддържа удобно за наблюдение ниво на яркостта при превключване на обективите. Интелигентният контрол на осветлението на микроскопа повишава комфорта и скоростта на работа на изследователя. Благодарение на „интелигентните“ функции няма нужда да се тормозите с настройките вниманието на потребителя е изцяло фокусирано върху решаването на неговите задачи.
Глава на микроскопа
Тринокулярна глава с коригирана до безкрайност оптика. Окулярните тръби могат да се въртят на 360°. Потребителят може да регулира разстоянието от очите на окулярите, за да отговаря на неговия ръст. В тринокулярната тръба е монтирана цифрова камера. Разделянето на лъчите е 50/50.
Основният комплект включва окуляри 10x/22 mm с регулиране на диоптъра и голямо разстояние от очите за работа с очила.
Револверна глава и обективи
Кодираната револверна глава за 5 обектива е ориентирана навътре: потребителят може да вижда поставения в оптичния път обектив, а пространството над предметната маса е свободно. В свободния слот може да бъде монтиран допълнителен обектив, за да се постигне още по-голямо увеличение. Парфокалното разстояние е 60 mm.
Над револверната глава има слот с пробка за монтиране на анализатор.
Поддържане на комфортни нива на яркост при превключване на увеличенията
Обективите с различно увеличение предават светлина с различна интензивност и поради това при всяка смяна на обектива трябва да се регулира яркостта на светлината. Освен това яркостта се увеличава рязко при превключване от обектив с по-голямо увеличение към такъв с по-малко увеличение. Рязкото увеличаване на яркостта уморява очите. MAGUS Bio 270T е оборудван с интелигентен контрол на яркостта. Оптималното ниво на яркостта на светлината се променя автоматично за всеки обектив, като така отстранява непредвидените промени в яркостта при промяна на увеличението. Тази функция оптимизира Вашата работа и намалява умората на очите.
Фокусиращ механизъм
С голям набор от обекти за изследване операторът постоянно използва бутона за фино фокусиране в своята работа. За да се намали напрежението в китката, микроскопът използва адаптивен механизъм за плавно движение. Бутонът за фино фокусиране разполага със специални вдлъбнатини за пръстите Ви. Финото фокусиране на фокуса е безпроблемно, а дясната ръка не се изморява.
Бутоните за грубо и фино фокусиране са коаксиални и разположени ниско. Изследователят може да постави ръцете си върху масата и да заеме комфортна поза пред микроскопа.
Бутонът за застопоряване при грубо фокусиране Ви предоставя възможност за бързо регулиране на микроскопа след смяна на обекта на изследването. Бутонът се намира от лявата страна на микроскопа на оста на механизма за фокусиране.
Пръстенът от дясната страна регулира усилието при грубото фокусиране. Потребителят настройва удобното за работа усилие.
Предметна маса
За осигуряване на ергономична работа с работната маса тя няма рейка за позициониране по оста X. Задвижваният с ремък механизъм осигурява възможност за плавно преместване на образеца. Държачът за образеца е закрепен с два винта и може да се отстранява лесно по време на ръчно сканиране.
Дългата ръкохватка за управление на предметната маса осигурява комфорт при работа на потребителя: ръкохватката лежи върху масата без напрежение.
Кондензер
Кондензерът на Abbe може да се настройва по височина и да се центрира. Тип на монтировката: лястовича опашка.
Пръстенът на кондензера регулира ирисовата диафрагма на апертурата. Тялото на кондензера има апертурна маркировка, а пръстенът има индикаторна маркировка. За постигане на контраст на всеки обектив е препоръчително да завъртате пръстена по такъв начин, че индексният маркер да съвпада с апертурния маркер на използвания обектив.
Осветление
Илюминаторът за преминаваща светлина съдържа светодиод 3 W. Илюминаторът на светлина на микроскопа има функция за регулиране на цветната температура в диапазона от 3000 до 7000 K. Потребителят избира удобна за очите му цветна температура и я променя лесно с един бутон, когато например, изследването на даден обект изисква промяна на светлината.
Животът на светодиода е 50 000 часа.
Осветление на Кьолер с преминаваща светлина
Източникът на светлина се намира в основата, в задната част на микроскопа, а светлината се насочва към колектора чрез огледало. Контрастът на изображението се регулира от апертурната диафрагма на кондензера, а осветената площ на полето се регулира от полевата диафрагма на колектора.
Осветлението на Кьолер подобрява качеството на изображението на наблюдаваната проба: всеки от обективите постига максимална разделителна способност, зрителното поле се осветява равномерно без затъмняване в краищата. Обектът на изследването е с отчетлив фокус и премахнати смущения в изображението.
Екран с течнокристален дисплей за състоянието
На екрана с течнокристален дисплей върху основата на микроскопа се показват увеличението на обектива, яркостта и цветната температура на източника на светлина и режима на работа (“спящ”, “еко”).
С помощта на екрана и два бутона ползващият микроскопа може да регулира яркостта, да избира цветната температура, да заключва регулирането на яркостта, да задава “спящия” режим и да настройва таймера за автоматично изключване.
Ергономична конструкция
Физическият дискомфорт предизвиква умора и намалява производителността. Ергономичната конструкция на микроскопа играе важна роля в ежедневните научни изследвания.
MAGUS Bio 270T предоставя комфорт на потребителя по време на работа. Чрез завъртане на главата на микроскопа потребителят избира височината на точката на гледане, за да не натоварва гърба и врата си.
Бутоните за фокусиране се намират в долната част на тялото. Потребителят не напряга ръцете си. Благодарение на плавното движение на механизма потребителят може да се фокусира безпроблемно върху обекта.
Понеже дългата ръкохватка за управление на предметната маса и бутонът за фино фокусиране са разположени в една и съща работна зона, микроскопът се управлява с минимално движение на ръката.
Микроскопът е оборудван със специална дръжка за пренасяне.
Конструкцията за скрито разполагане на захранващия адаптер и захранващия кабел подобрява естетиката на работното място и безопасността при пренасяне на микроскопа, както и опростява съхранението на уреда.
Принадлежности
Има набор от принадлежности, конструирани за този микроскоп. Допълнителните обективи осигуряват допълнително увеличение.
Окулярите разширяват диапазона на увеличение на микроскопа. Допълнителни окуляри ви помагат да увеличите максимално потенциала на обектива, който използвате по-често.
Фазовоконтрастното устройство, илюминаторът за отразена светлина, кондензерите за тъмно поле и устройството за поляризация разширяват контрастните техники и позволяват изучаването на невидими в светлото поле обекти.
Цифрова камера пренася изображението от микроскопа на монитор, запаметява файлове и софтуер, който прави измервания на образци в реално време.
За измерване на обекти се използва калибрационен образец, който може да се комбинира с окуляр със скала или със софтуера на камера.
Основни характеристики:
- Наблюдение на прозрачни и полупрозрачни образци по метода на светлото поле с пропусната светлина
- Тринокулярната глава с вертикална тръба за монтиране на цифрова камера и регулиране на височината за наблюдаващия разделяне на лъча на светлината 50/50
- Кодирана револверна глава: яркостта на източника на светлина се задава автоматично в зависимост от избрания обектив
- Илюминаторът за преминаваща светлина е енергоспестяващ светодиод 3 W със срок на експлоатация до 50 000 часа
- Осветление на Кьолер за преминаваща светлина, центриран и височинно регулируем кондензер с апертурни маркировки на обектива
- Система за интелигентно управление на осветлението: автоматичен избор на яркост, заключване на затъмняването, таймер за автоматично изключване, течнокристален екран за работното състояние
- Предметна маса без рейка за позициониране по оста Х с дълга ръкохватка за управление за удобна работа
- Ергономична стойка с дръжка за пренасяне и скрито разположение на захранващия кабел и захранващия адаптер
- Широка гама съвместими допълнителни принадлежности
Комплектът включва:
- Стойка с вградено захранване, светлинен източник за преминаваща светлина, фокусиращ механизъм, предметна маса, монтировка за кондензер и револверна глава
- Кондензер Abbe
- Тринокулярна глава
- Коригиран до безкрайност планахроматичен обектив: 4x/0,10, парфокална височина 60 mm
- Коригиран до безкрайност планахроматичен обектив: 10x/0,25, парфокална височина 60 mm
- Коригиран до безкрайност планахроматичен обектив: 40x/0,65, парфокална височина 60 mm
- Коригиран до безкрайност планахроматичен обектив: 100x/1,25 маслен (пружинно натоварен), парфокална височина 60 mm
- Окуляр 10x/22 mm с голямо разстоянието от очите и регулиране на диоптъра (2 бр.)
- Чашка за окуляр (2 бр.)
- Светлинен филтър
- Адаптер за камера с С-образна монтировка
- Захранващ адаптер и захранващ кабел на микроскопа
- Покривало против прах
- Ръководство за потребителя и гаранционна карта
Предлагат се по заявка:
- Окуляр 10x/22 mm със скала
- Окуляр 10x/22 mm с решетка
- Окуляр 10x/22 mm с мерник
- Окуляр 12,5x/17,5 mm (2 бр.)
- Окуляр 15x/16 mm (2 бр.)
- Окуляр 20x/12 mm (2 бр.)
- Коригиран до безкрайност планахроматичен обектив: 20x/0,40, парфокална височина 60 mm
- Фазовоконтрастно устройство: фазовоконтрастен кондензер, допълнителен телескоп за центриране, комплект от фазови обективи
- Кондензер за тъмно поле NA 0,7–0,9
- Имерсионен кондензер за тъмно поле NA 1,3–1,26
- Илюминатор за отразена светлина
- Устройство за поляризация
- Цифрова камера
- Калибрационен образец
- Монитор
| Марка | MAGUS |
| Гаранция | 5 лет |
| EAN | 5905555019475 |
| Размер на опаковката (Д x Ш x В) | 76x48x51 cm |
| Транспортно тегло | 17.8 kg |
| Тип | биологичен, светлина/оптичен |
| Глава | тринокулярни |
| Глава | с разпределение 50/50 на светлинния поток, глава Gemel (Siedentopf, завъртане на 360°) |
| Ъгъл на наклон на главата | 30 ° |
| Увеличение, x | 40–1000 при базовата конфигурация (*опция: 40–1250/1500/2000) |
| Диапазон на увеличението | от 800x до 1280x |
| Диаметър на тръбата на окуляра, mm | 30 |
| Окуляри | 10x/22, голямо разстояние от очите (*опция: 10x/22 със скала, 10x/22 с решетка, 10x/22 с мерник, 12,5x/17,5, 15x/16, 20x/12) |
| Обективи | планахроматични, коригирани до безкрайност: 4x/0,10 10x/0,25 40x/0,65 100xs/1,25 маслени (*опция: 20x/0,40) парфокална височина 60 mm |
| Револверна глава | 5 обектива, кодирани |
| Работна дистанция, mm | 30 (4x) 10,2 (10x) 1,5 (40x) 0,2 (100xs) |
| Разстояние между окулярите, mm | 47 — 78 |
| Предметна маса, mm | 235x150 |
| Диапазон на движение на предметната маса, mm | 78/54 |
| Характеристики на предметната маса | двуосова механична предметна маса, без рейка за позициониране |
| Регулиране на диоптъра на окуляра, диоптри | ± 5D на всеки от окулярите |
| Регулиране на диоптъра на окуляра | yes |
| Кондензатор | кондензер Abbe, N.A. 0,9, с регулируем център, регулируема височина, регулируема диафрагма и монтировка „лястовича опашка“ |
| Диафрагма | диафрагма с регулируема апертура, полева диафрагма с регулируем ирис |
| Фокусиране | коаксиален, грубо (32 mm, 28 mm/кръг, със застопоряващ бутон и бутон за регулиране на затягането) и фино (0,001 mm) |
| Осветление | светодиодно |
| Регулиране на яркостта | yes |
| Захранване | 100–240 V, 50/60 Hz, променливотокова мрежа, захранващият адаптер за променлив/постоянен ток се намира в специално гнездо на гърба на стойката |
| Тип на светлинния източник | светодиод 3 W, с регулиране на цветната температура (3000–7000 K) |
| Светлинни филтри | да |
| Диапазон на работната температура, °C | 5 — 35 |
| Допълнително | автоматично регулиране на яркостта при превключване на обективите, екран с течнокристален дисплей за състоянието, „спящ“ режим, режим „еко“ |
| Възможност за свързване на допълнително оборудване | фазовоконтрастно устройство (кондензер и обективи), кондензер за метода на тъмното поле в имерсионно масло (сух или в масло), устройства за поляризация (поляризатор и анализатор), илюминатор за отразена светлина |
| Потребителско ниво | опитни потребители, за професионалисти |
| Ниво на трудност на сглобяване и монтаж | сложен |
| Приложение | лабораторно/медицинско |
| Място на осветлението | долно |
| Метод за изследване | на светлото поле |
| Торбичка/калъф/чанта в комплект | покривало против прах |

Отзиви към продукт